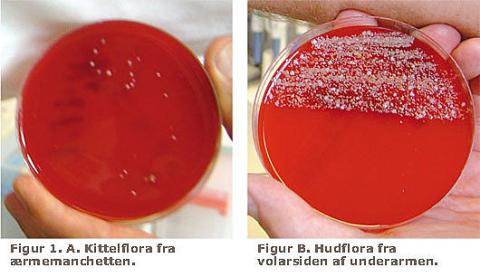

Kittelærmerne klippes af [1], men eneste evidens er, at man [2] mener, at manchetten på ærmerne er et af de steder, hvor der er størst sandsynlighed for, at kitlen kontamineres med mikroorganismer, og at egne observationer skal have vist, at langærmede kitler besværliggør en sufficient hånddesinfektion.
Den citerede artikel [3] viser imidlertid, at kontaminationen af kitlerne var meget beskeden (ca. 1 CFU/cm2) i overensstemmelse med vore erfaringer (Figur 1A). Demonstrationen af håndvask/desinfektion i en tidligere artikel [4], hvor albuerne bøjes og armene rækkes frem, medfører dog, at ærmemanchetten glider 5-6 cm tilbage, så håndleddene er frie til proceduren.
I CAS-NYT nr. 103 fra 2007 vurderes evidensstyrken til C, dvs. dårlig evidens for at anbefale eller fraråde. En systematisk engelsk gennemgang af litteraturen om uniformers betydning for overførsel af sygehusinfektioner konkluderer, at det er der ikke evidens for [5], og at hovedparten af de bakterier, som kitlerne kontamineres med, ikke er patogene og stammer fra bærerens hud eller fra omgivelserne. En leder i The Lancet [6] kritiserede ligeledes en kortærmekittelbeslutning fra det engelske sundhedsministerium som værende gætteri, og vi har heller ikke fundet evidens, der støtter kittelrevolutionen.
Kitlen anvendes til at beskytte bærerens personlige tøj og hud, og tørre kitler har 90% effektiv filterfunktion for bakterier [7] og reducerer også antallet af frigivne, luftbårne bakterier fra normale personer [8].
Mennesket har 200 g mikroorganismer (hovedsageligt bakterier) på huden, hvor de findes på overhuden på døde pladeepitelceller, i talgkirtlerne og i svedkirtlerne (Figur 1B). Vi afstøder daglig ca. 100 millioner pladeepitelceller, hvor ca. 4% bærer stafylokokker, corynebakterier og propionebakterier. Efter håndvask afstøder man flere bakterieholdige epitelceller, hvilket skyldes affedtningen af huden [9]. Så længe man anvender langærmede kitler, er det foruden hoved-hals kun de to hænder, der uhindret afgiver bakterieholdige epitelceller og kan blive koloniseret med bakterier fra omgivelserne, fortrinsvis stafylokokker. Hvis man bruger kortærmede kitler, vil de eksponerede arme betyde en meget større hudoverflade til afgivning af bakterieholdige hudceller og som substrat for kolonisering fra omgivelserne. Det er vel meningen, at man nu skal anvende spritdesinfektion både af hænder og de frie arme, og den større overflade vil så give en tilsvarende større absorption af sprit. Sygeplejersker kan være bærere af S. aureus på volarsiden af underarmene [10], og patienter og personale bliver koloniseret med multiresistente koagulasenegative stafylokokker (MRSE), som selekteres af antibiotikaforbruget [11]. Nogle antibiotika omstiller hudfloraen på 2-3 dage til MRSE, som holder sig omkring en måned efter ophør af behandlingen, og MRSE er en af de hyppigste årsager til nosokomielle infektioner [12, 13], og nosokomiel spredning af MRSE-kloner forekommer, og de persisterer sandsynligvis hos patienter og personale [14].
Sygehuspersonale, der har arbejdet i udlandet, hvor der er højere prævalens af methicillinresistente S. aureus (MRSA), har risiko for at blive koloniseret i længere tid [15], og af den grund screener vi dem for MRSA. Den øgede eksponering af hudoverfladen ved brug af kortærmede kitler vil øge muligheden for kolonisering med multiresistente bakterier herunder MRSE og MRSA, og for at udskille disse til omgivelserne. Indførelse af kortærmede kitler, som plejepersonalet desværre længe har brugt, er ikke evidensbaseret, men åbner nye risici for spredning af bakterier til personalet og fra personalet til patienterne.
Referencelisten kan rekvireres fra forfatterne.